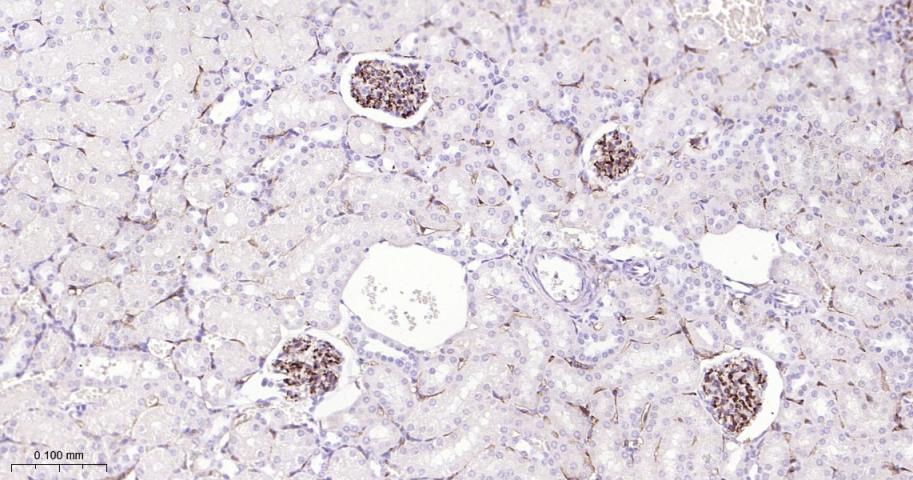
CD34重组兔单抗

CD34 Recombinant Rabbit mAb (一抗) - WB,IHC-P,IHC-F,IF,IP | Bioss
Rrmab?兔单抗

货号:bsm-60829R
产品详情
相关标记
相关产品
相关文献
常见问题
概述
产品编号
bsm-60829R
产品类型
重组兔单抗、mIHC精品抗体
英文名称
CD34 Recombinant Rabbit mAb
中文名称
CD34重组兔单抗
英文别名
CD34_HUMAN; CD34;
抗体来源
Rabbit
免疫原
KLH conjugated synthetic peptide derived from human CD34: 350-385
亚型
IgG
性状
Liquid
纯化方法
affinity purified by Protein A
克隆类型
Recombinant
克隆号
4G1
理论分子量
39 kDa
检测分子量
105 kDa
浓度
1mg/ml
储存液
0.01M TBS(pH7.4) with 1% BSA, 0.03% Proclin300 and 50% Glycerol.
研究领域
Cardiovascular > Angiogenesis > Endothelial Cell Markers
Cardiovascular > Heart > Cardiogenesis > Stem cells
Developmental Biology > Lineage specification > Mesoderm
Immunology > Cell Type Markers > CD > Myeloid Cells
Neuroscience > Cell Type Marker > Neuron marker > Soma marker
Stem Cells > Endothelial Progenitors > Endothelial Markers
Stem Cells > Hematopoietic Progenitors > Hematopoietic Stem Cells > HSC markers
Stem Cells > Hematopoietic Progenitors > Surface Molecules
SWISS
Gene ID
保存条件
Shipped at 4℃. Store at -20℃ for one year. Avoid repeated freeze/thaw cycles.
注意事项
This product as supplied is intended for research use only, not for use in human, therapeutic or diagnostic applications.
产品介绍
造血干细胞标志物
内皮标志物
肿瘤生物标志物
细胞表面的唾液粘蛋白。
内皮标志物
肿瘤生物标志物
细胞表面的唾液粘蛋白。
背景资料
The highly glycosylated 75-120 kD antigen CD34 is possibly an adhesion molecule with a putative role in early hematopoiesis by mediating the attachment of stem cells to the bone marrow extracellular matrix or directly to stromal cells. It could act as a scaffold for the attachment of lineage specific glycans, allowing stem cells to bind to lectins expressed by stromal cells or other marrow components. CD34 is thought to have a role in presenting carbohydrate ligands to selectins. The intracellular chain of the CD34 antigen is a site of phosphorylation by activated protein kinase C, suggesting a putative role in signal transduction. Two isoforms of CD34 have been reported to be generated by alternative splicing. CD34 is highly expressed on hematopoietic progenitors, as well as on endothelial cells, brain, and testis. Staining for CD34 has been used to measure angiogenesis, which reportedly predicts tumor recurrence.

产品应用
| 应用 | 已检合格种属 | 预测种属 | 推荐稀释比例 |
|---|---|---|---|
| WB | Human | Mouse, Rat | 1:1000-5000 |
| IHC-P | Human, Mouse, Rat | 1:200-1000 | |
| IHC-F | Human, Mouse, Rat | 1:200-1000 | |
| IF | Mouse, Rat | Human | 1:200-1000 |
| IP | Human, Mouse, Rat | 1:20-100 |
交叉反应
交叉反应: Human, Mouse, Rat
相关产品
暂无相关产品
靶标
基因名
CD34
蛋白名
Hematopoietic progenitor cell antigen CD34
亚细胞定位
Membrane; Single-pass type I membrane protein.
组织特异性
Selectively expressed on hematopoietic progenitor cells and the small vessel endothelium of a variety of tissues.
翻译后修饰
Highly glycosylated.
Phosphorylated on serine residues by PKC.
Phosphorylated on serine residues by PKC.
相似性
Belongs to the CD34 family.
功能
Possible adhesion molecule with a role in early hematopoiesis by mediating the attachment of stem cells to the bone marrow extracellular matrix or directly to stromal cells. Could act as a scaffold for the attachment of lineage specific glycans, allowing stem cells to bind to lectins expressed by stromal cells or other marrow components. Presents carbohydrate ligands to selectins.
同靶标产品
相关文献
提示: 发表研究结果有使用 bsm-60829R 时请让我们知道,以便我们可以引用参考文章。作为回馈,资料提供者将获得我们送上的小礼品。